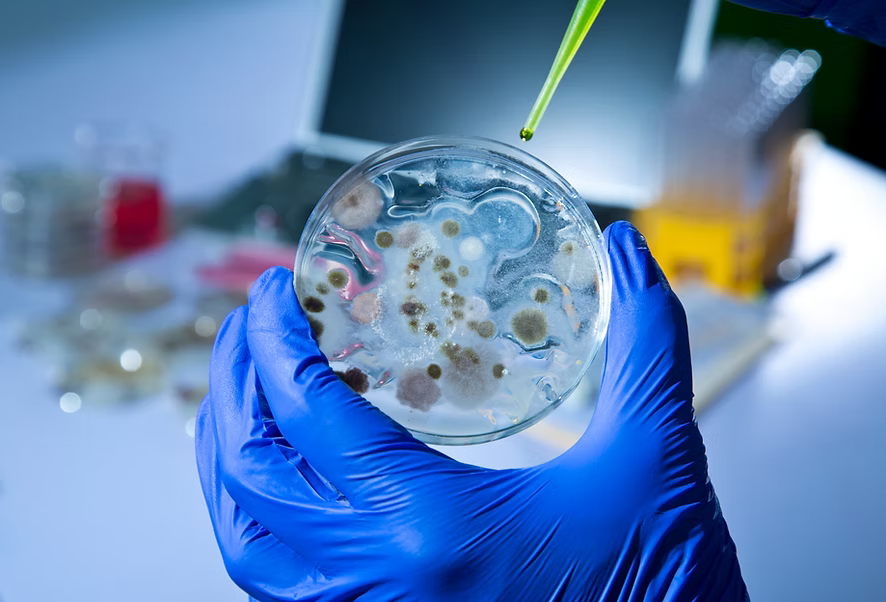
Bakterie

Problem
Obecne rozwiązania są niszczące dla zdrowia publicznego
Superbakterie* stały się 10 razy bardziej odporne na środki dezynfekujące na bazie alkoholu w ostatniej dekadzie, co jest poważnym problemem dla szpitali, które polegają na tych środkach czyszczących, aby zapobiec infekcjom. Nadużycie antybiotyków - z których 50% jest wykorzystywane w hodowli zwierząt - dodatkowo przyspiesza rozwój superbakterii. Przewiduje się, że jeśli nie zostaną sprawdzone, infekcje oporne na antybiotyki spowodują 10 milionów zgonów rocznie do 2050 roku, podkreślając pilną potrzebę bezpieczniejszych, bardziej skutecznych alternatyw.
Superbakterie* stały się 10 razy bardziej odporne na środki dezynfekujące na bazie alkoholu w ostatniej dekadzie, co jest poważnym problemem dla szpitali, które polegają na tych środkach czyszczących, aby zapobiec infekcjom. Nadużycie antybiotyków - z których 50% jest wykorzystywane w hodowli zwierząt - dodatkowo przyspiesza rozwój superbakterii. Przewiduje się, że jeśli nie zostaną sprawdzone, infekcje oporne na antybiotyki spowodują 10 milionów zgonów rocznie do 2050 roku, podkreślając pilną potrzebę bezpieczniejszych, bardziej skutecznych alternatyw.
Rozwiązanie
Nasza potężna formuła eliminuje superbakterie raz na zawsze.
 Wykorzystując zastosowaną nanotechnologię, nasyciliśmy nadtlenek wodoru i nanostruktury wody o właściwościach chemicznych, które umożliwiają im przenikanie patogenów opornych na antybiotyki i zatrzymanie ich wzrostu - bez toksycznych chemikaliów.
Wykorzystując zastosowaną nanotechnologię, nasyciliśmy nadtlenek wodoru i nanostruktury wody o właściwościach chemicznych, które umożliwiają im przenikanie patogenów opornych na antybiotyki i zatrzymanie ich wzrostu - bez toksycznych chemikaliów.
Nasze rozwiązanie zapobiega wybuchom chorób u ludzi i zwierząt, dramatycznie zmniejszając zależność od antybiotyków, zwłaszcza u zwierząt gospodarskich. Ta technologia jest potężną obroną pierwszej linii przed superbakteriami, chroniącą zdrowie i zapewniającą bezpieczną przyszłość dla wszystkich.
